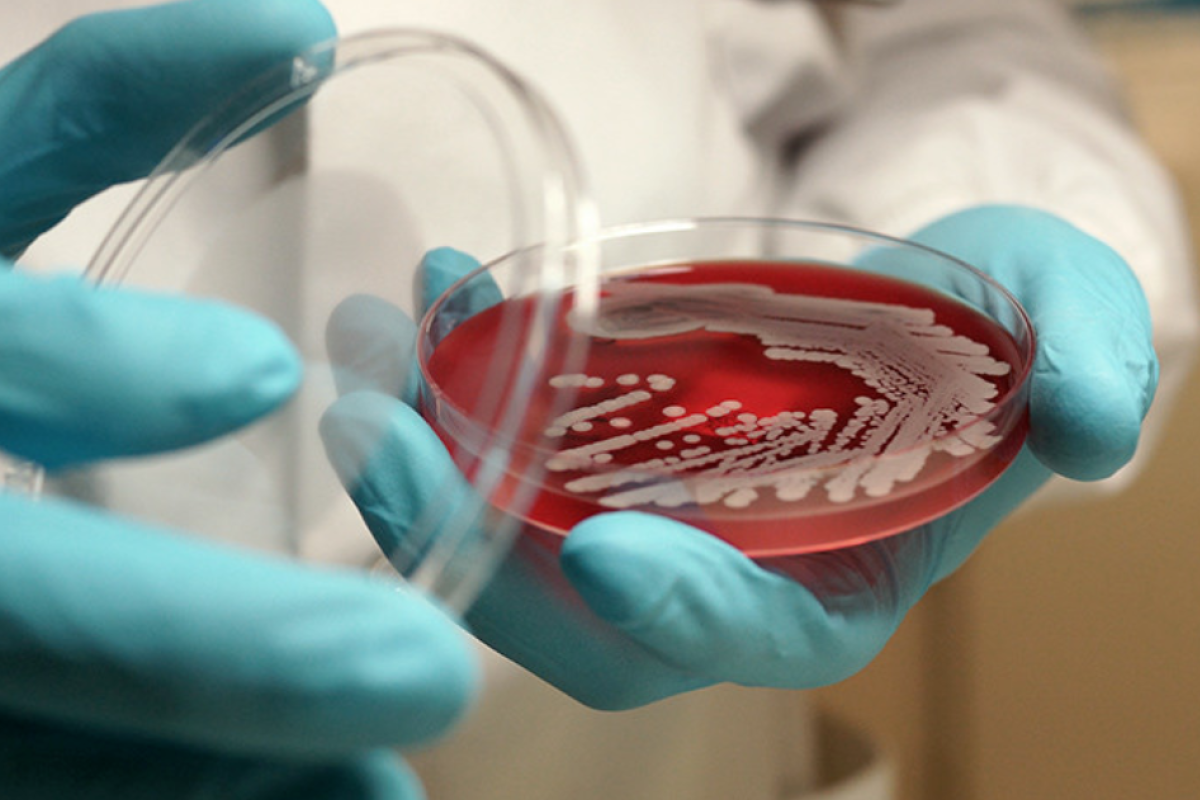

В Тернополе в парке "Топильче" зафиксировали случай сибирской язвы. В зооуголке парка погиб пони, Результаты исследования подтвердили предварительный диагноз.
Зооуголок, где погибло инфицированное животное, перевели на карантин. На территории зооуголка и парка "Топильче" взяли на исследование пробы воды и почвы на наличие спор сибирской язвы. Об этом сообщает Государственная служба Украины по вопросам безопасности пищевых продуктов и защиты потребителей, передает Час Пик.
"В ночь с 27 на 28 сентября 2021 года в зооуголке парка "Топильче" коммунального предприятия "Объединение парков культуры и отдыха г. Тернополь" (г. Тернополь) погиб пони, о чем 28.09.2021 года было сообщено в Тернопольскую городскую больницу ветеринарной медицины. На место происшествия выехали специалисты больницы и Сумской региональной государственной лаборатории Госпродпотребслужбы.
Специалисты отобрали необходимые пробы, которые были направлены в Тернопольскую региональную государственную лабораторию Госпродпотребслужбы для исследования на сибирскую язву. По результатам исследования установлено заболевание сибирской язвой. Патологический материал для подтверждения диагноза передан в Государственный научно-исследовательский институт по лабораторной диагностике и ветеринарно-санитарной экспертизе (город Киев), который 04.10.2021 года подтвердил диагноз", - говорится в сообщении.
На территории зооуголка провели дезинфекцию, место, где жил и гулял пони, обожгли огнем. Всех других животных вакцинировали от сибирской язвы, а работникам зооуголка назначили курс антибиотиков.
На внеочередном заседании государственной чрезвычайной противоэпизоотической комиссии при Тернопольской ОГА принято решение считать эпизоотическую ситуацию на территории Тернополя неблагополучной, а на территории области - угрожающей.
Жителей города призвали прекратить кормить с рук животных в зооуголке, а также не выгуливать рядом собак, поскольку это может быть опасным.
По информации Центра общественного здоровья Минздрава Украины, сибирская язва не передается от человека к человеку, ею можно заразиться только через контакт с инфицированным животным.
Заражение человека сибирской язвой возникает вследствие:
- проникновения возбудителя через поврежденную кожу (царапины, ссадины, мелкие порезы) или слизистые оболочки при уходе за больными животными;
- разделки туш, свежевания и захоронения трупов погибших животных;
- контакта с различными видами сырья, полученного от больных животных;
- употребление в пищу мяса больных животных;
- аспирационного и трансмиссивного (через укусы кровососущих насекомых) путей;
- прикосновения к зараженным предметам или почвы.
















